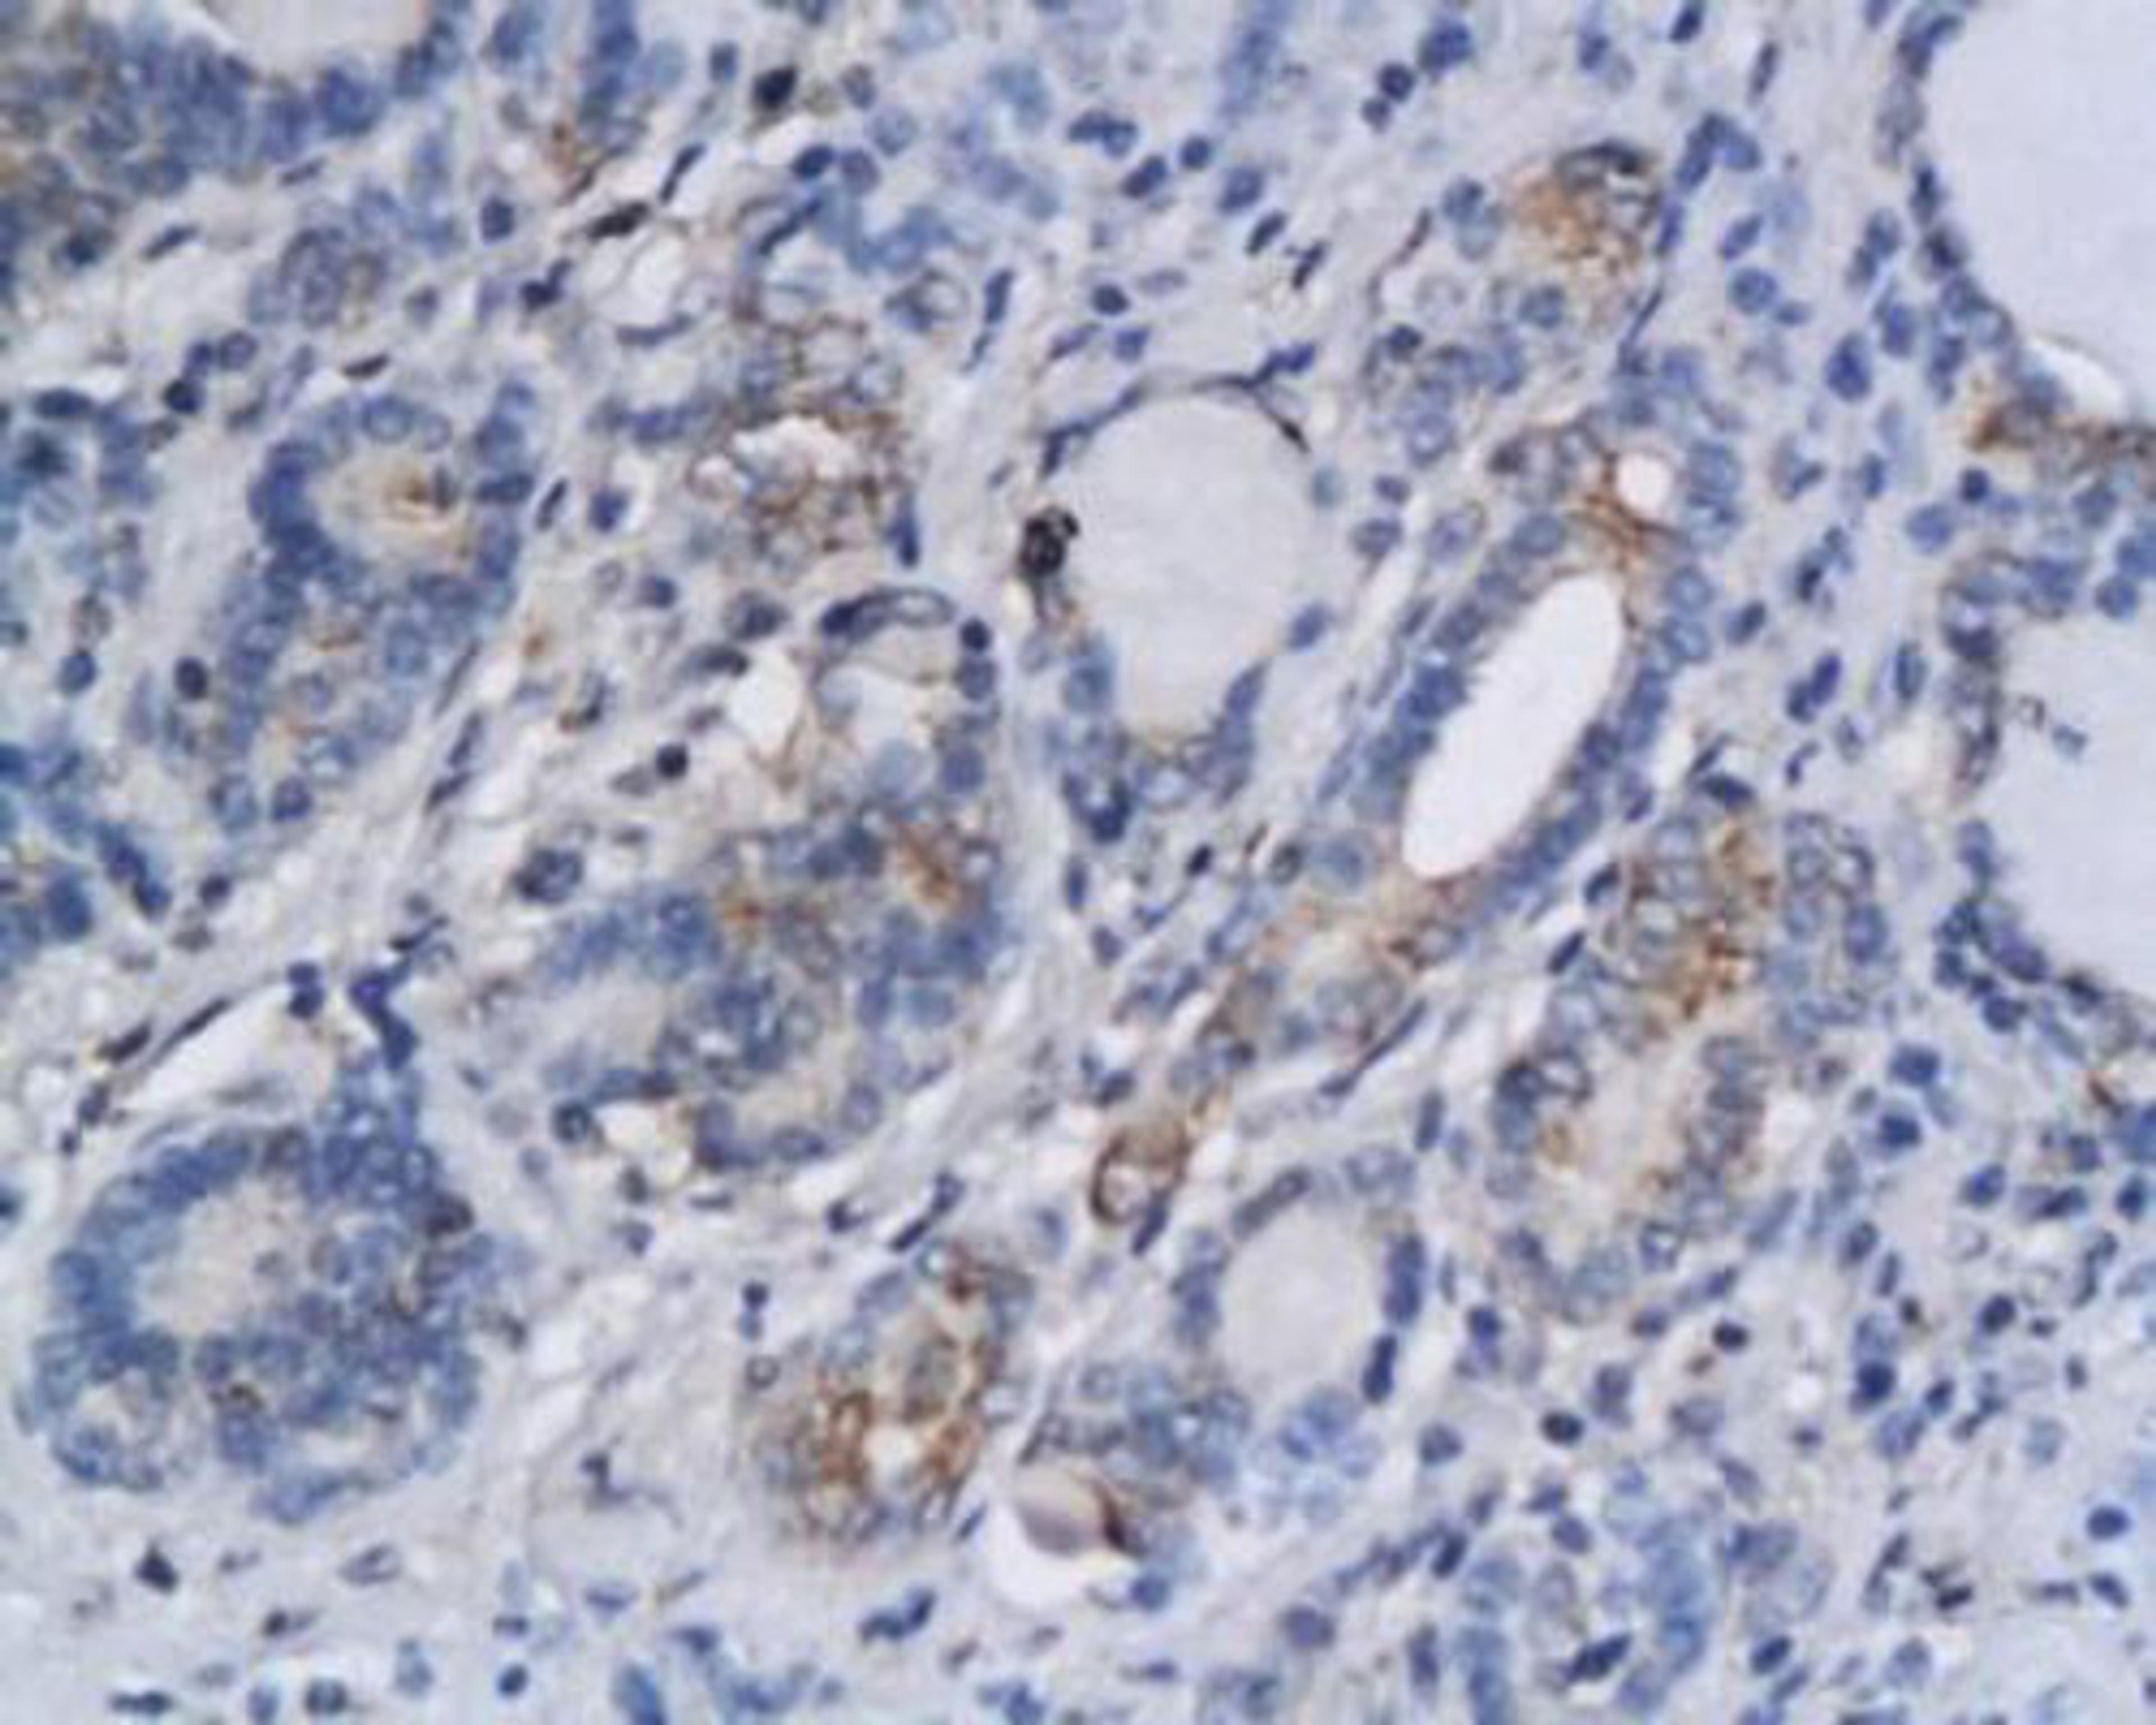
Immunohistochemical analysis of paraffin-embedded human thyroid cancer tissue using AHR antibody

MOUSE ANTI RABBIT GAPDH
- Manufacturer
- Bio-Rad
- Catalog Number
- MCA4739
- Host
- Mouse
- Reactivity
- African Green Monkey, Cat (Feline), Chicken, Dog (Canine), Human, Mouse, Pig (Swine), Rabbit (Lapine), Rat, Sheep (Ovine), Tube-Nosed Bat, Vertebrate, Xenopus, Crucian Carp
- Applications
- ELISA, Immunofluorescence, Immunohistochemistry (Frozen Sections), Immunoprecipitation, Western Blotting




![Western blot - Anti-Brd4 antibody [EPR5150(2)] (ab128874)](https://cdn.sanity.io/images/f5b6mtfn/antibodies-prod/8a64c326423fe63ed54fba5ae7cd69b112540057-500x724.jpg?w=3840&q=75&fit=clip&auto=format)

![Immunocytochemistry/Immunofluorescence: HIF-1 alpha Antibody (ESEE122) [NB100-131] - Detection of HIF-1 alpha (red dye) in a cell cytospin from a lavage of a murine skin pouch infected with Staph Aureus, using NB100-131. Blue dye is DAPI nuclear staining. Photos courtesy of Susan Alexander and Hattie Gresham, PhD.](https://cdn.sanity.io/images/f5b6mtfn/antibodies-prod/9a5eaa1ae890e12b39ea26f7ba755cec1329009d-400x320.jpg?w=3840&q=75&fit=clip&auto=format)
![Western Blot: mCherry Antibody (1C51) [NBP1-96752] - WB assay of the crude extract of Hek293 cells transfected with pFin-EF1-mCherry vector (lane +) and an equal amount of protein extract from untransfected Hek293 cells (lane -). NBP1-96752 binds a major band running at about 28kDa corresponding to intact full-length mCherry. The two other bands are clearly processed forms of mCherry as they are not present in non-transfected Hek293 cells.](https://cdn.sanity.io/images/f5b6mtfn/antibodies-prod/65308a977f52d4cbd356ba400bf1566e5a9ea3a5-214x400.jpg?w=3840&q=75&fit=clip&auto=format)
![Chromatin Immunoprecipitation (ChIP): Nrf2 Antibody [NBP1-32822] - ChIP was performed with HepG2 chromatin extract and 5 ug of either normal rabbit IgG or anti-NRF2 antibody. The precipitated DNA was detected by PCR with primer set targeting to GCLC gene locus.](https://cdn.sanity.io/images/f5b6mtfn/antibodies-prod/433b27e3cbbe622a450d5dd11dccf6e7cac987a1-400x262.jpg?w=3840&q=75&fit=clip&auto=format)
![Immunocytochemistry/Immunofluorescence: Abeta 40 Antibody [NB300-225] - The Abeta 40 antibody was tested in SH-SY5Y cells at a 1:1000 dilution against Dylight 488 (Green). Alpha tubulin and nuclei were counterstained against Dylight 550 (Red) and DAPI (Blue), respectively.](https://cdn.sanity.io/images/f5b6mtfn/antibodies-prod/0a8226334cfc60fe389a2c18efa1dcf19bce72ff-400x290.jpg?w=3840&q=75&fit=clip&auto=format)
![Western Blot: PARP Antibody (194C1439) [Azide Free] [NBP2-27335] - Analysis of cleaved PARP in staurosporine-treated Jurkat cells at various time points, using this antibody. The band corresponding to cleaved PARP is only seen in the treated samples. anti-mouse Ig HRP conjugate was used in this test.](https://cdn.sanity.io/images/f5b6mtfn/antibodies-prod/1f608cd464e8da0012d48174d8f5cbeaf644b3b4-278x400.jpg?w=3840&q=75&fit=clip&auto=format)
![Immunohistochemistry: Reelin Antibody (G10) [NB600-1081] - Mouse anti-Reelin staining of embryonic cerebral cortex at 15 days in utero, with the pial surface above and the ventricle below. The positive zone is the Cajal-Retzius cell layer in the marginal zone, positive for reelin using NB600-1081.](https://cdn.sanity.io/images/f5b6mtfn/antibodies-prod/25fa538e7133421156e0dd1e1f9fdaf6d726e3ac-400x255.jpg?w=3840&q=75&fit=clip&auto=format)
![Immunohistochemistry: p53 [p Ser15] Antibody [NB100-92601] - Immunohistochemistry (IHC) analyzes of p-p53 (S15) antibody in paraffin-embedded human breast carcinoma tissue.](https://cdn.sanity.io/images/f5b6mtfn/antibodies-prod/d17b229364516b534efcc3323fb656dbd1529c77-400x265.jpg?w=3840&q=75&fit=clip&auto=format)
![Immunohistochemistry-Frozen: ER alpha/NR3A1 Antibody (33) [NB300-560] - Human breast carcinoma (B) and magnified section (C) compared with an isotype control (A).](https://cdn.sanity.io/images/f5b6mtfn/antibodies-prod/1afb680644ce7a111fd62453aa11a0ff061f2096-400x117.jpg?w=3840&q=75&fit=clip&auto=format)
![Immunohistochemistry-Paraffin: CA125/MUC16 Antibody (X75) [NB600-1468] - Analysis in antigen in serosal ovarian adenocarcinoma.](https://cdn.sanity.io/images/f5b6mtfn/antibodies-prod/116491b67c165678ae205b44fac4dcbead0ce2e9-400x286.jpg?w=3840&q=75&fit=clip&auto=format)
![Western Blot: CEBP alpha Antibody (15C8) [NB600-1438] - Analysis of transfected 293T cells.](https://cdn.sanity.io/images/f5b6mtfn/antibodies-prod/46ddecd48f14c421b7b97b315d7516f2fe3ee38b-400x400.jpg?w=3840&q=75&fit=clip&auto=format)


